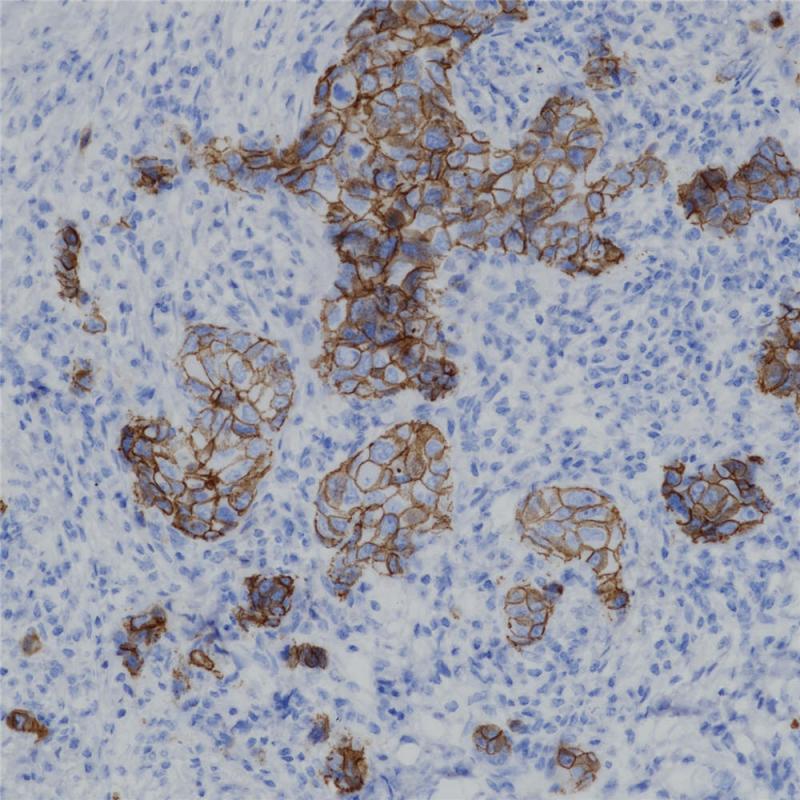
乳腺癌 p120 (BP6075) 染色

产品中心

结肠 p120 (BP6075) 染色
乳腺癌 p120 (BP6075) 染色
p120 重组兔单克隆抗体
Alpha-catenin和beta-catenin与E-cadherin的胞内区域进行结合,而p120则与E-cadherin的近膜区结合,这种结合非常牢固。在细胞中,p120直接与E-cadherin的羧基端结合,并且可能通过该模式与其他cadherins结合。 在大肠癌中,p120蛋白往往因为细胞内E-cadherin蛋白的缺失而发生定位变化,在胞浆内形成蓄积。研究表明,p120可以用于区分乳腺小叶癌和导管癌,并且可进一步用于区分原位的低分化导管癌与乳腺小叶癌。 研究进一步表明,p120抗体的表达可以用于浸润性乳腺癌的转归,一般p120表达强预示患者预后不佳。
Specifications
- 目录号
- BX50070
- 克隆号
- BP6075
- 阳性对照
- 结肠
- 亚细胞定位
- 细胞膜/细胞质
- 组织类型
- FFPE
- 修复方式
- HIER
- 稀释比
- 1:100-1:200
- 规格
- 100μl/vial, 1ml/vial
- 用途
- RUO
Reference
1.Talvinen K, et al. Altered expression of p120 catenin predicts poor outcome in invasive breast cancer. J Cancer Res Clin Oncol. 2010 Sep; 136(9):1377-87.
2.Chivukula M, et al. Pleomorphic lobular carcinoma in situ (PLCIS) on breast core needle biopsies: clinical significance and immunoprofile. Am J Surg Pathol. 2008 Nov; 32(11):1721-6.


